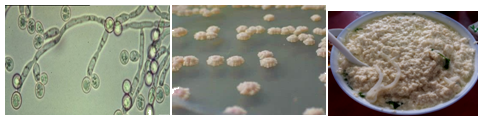
2019年中西醫(yī)執(zhí)業(yè)助理醫(yī)師輔導精華：陰道炎

2019新的開始,愿你努力一些,有計劃、有步驟地去做自己,活出自己的本色。小編在這里溫馨提醒你,備考2019年中西醫(yī)結(jié)合助理醫(yī)師考試的你該開始學習啦!距離考試越來越近,在此醫(yī)學教育網(wǎng)為大家送福利!價值99元精選課程限時0元免費搶,是真的0元免費搶!趕快查看下方課程都包含哪些內(nèi)容吧!
近期熱點:【3月7日】譚楊老師關(guān)于2019年中西醫(yī)∣助理醫(yī)師備考問題解答免費直播
2019年中西醫(yī)執(zhí)業(yè)助理醫(yī)師輔導精華:各種陰道炎的臨床表現(xiàn)
(一)滴蟲陰道炎的臨床表現(xiàn)
1.癥狀 白帶多,呈灰黃色稀薄泡沫狀。陰道口及外陰瘙癢,或有灼熱,疼痛,性交痛等。
2.體征 陰道黏膜點狀充血,后穹隆有多量灰黃色稀薄膿性分泌物,多呈泡沫狀。
(二)外陰陰道假絲酵母菌病(念珠菌)的臨床表現(xiàn)
1.癥狀 白帶增多,呈白色凝乳狀或豆渣樣。外陰及陰道奇癢灼痛、性交痛。
2.體征 陰道黏膜附有白色膜狀物,擦去后見黏膜充血紅腫。
(三)細菌性陰道病的臨床表現(xiàn)
1.癥狀 分泌物增多,灰白色稀薄,有魚腥臭味。性交后加重,可伴有輕度外陰瘙癢或燒灼感。墜脹,有灼痛感、瘙癢。尿痛及性交痛。
2.體征 檢查可見陰道黏膜無紅腫、充血等炎癥反應(yīng),分泌物易從陰道壁拭去。
加德納菌
(四)萎縮性陰道炎的臨床表現(xiàn)
1.癥狀 陰道分泌物增多,多呈水狀,外陰瘙癢,灼熱,干澀感。
2.體征 外陰、陰道潮紅、充血、萎縮,呈老年性改變(雌激素下降引起),黏膜皺襞消失,上皮平滑、菲薄。
2019年中西醫(yī)執(zhí)業(yè)助理醫(yī)師輔導課程正在火熱招生中,網(wǎng)絡(luò)課+面授課,全方位幫助你盡早通過考試,考試內(nèi)容繁雜?考點太多記不住?醫(yī)學教育網(wǎng)專業(yè)師資憑借多年的培訓經(jīng)驗,幫助成千上萬考生順利走上醫(yī)考之路,并且都取得斐然成績,多種班次組合,總有一款適合你!快速購買2019年輔導課程>>

- · 【考后關(guān)注】2024中西醫(yī)助理醫(yī)師資格筆試考后都需要關(guān)注什么?看本篇!
- · 遼寧大連市甘井子區(qū)2025年中西醫(yī)助理醫(yī)師醫(yī)師報名備案8月31日截止!
- · 廣西考區(qū)柳州考點領(lǐng)取2024年中西醫(yī)助理醫(yī)師報考畢業(yè)證通知
- · 內(nèi)蒙古通遼市2024年中西醫(yī)助理實踐技能考試網(wǎng)上繳費最后1天
- · 內(nèi)蒙古興安盟考點2024年中西醫(yī)助理醫(yī)師實踐技能考試繳費最后1天
- · 內(nèi)蒙古2024年中西醫(yī)助理醫(yī)師實踐技能考試繳費最后1天
- · 陜西考區(qū)2024中西醫(yī)助理醫(yī)師實踐技能網(wǎng)上繳費最后1天
- · 江蘇考區(qū)2024中西醫(yī)助理醫(yī)師實踐技能網(wǎng)上繳費今日截止
- · 重慶考區(qū)2024年中西醫(yī)助理醫(yī)師實踐技能網(wǎng)上繳費最后一天
- · 江蘇宿遷考點2024年中西醫(yī)助理醫(yī)師實踐技能考試網(wǎng)上繳費時間












掃一掃立即下載


